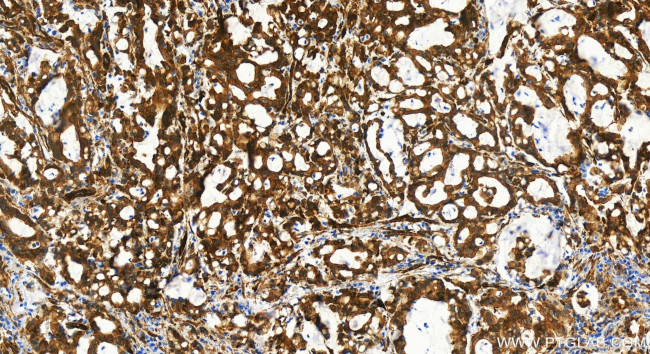
BAG3 Antibody in Immunohistochemistry (Paraffin) (IHC (P))

Search
Proteintech
BAG3 Recombinant Rabbit Monoclonal Antibody (240860F12)
{{$productOrderCtrl.translations['antibody.pdp.commerceCard.promotion.promotions']}}
{{$productOrderCtrl.translations['antibody.pdp.commerceCard.promotion.viewpromo']}}
{{$productOrderCtrl.translations['antibody.pdp.commerceCard.promotion.promocode']}}: {{promo.promoCode}} {{promo.promoTitle}} {{promo.promoDescription}}. {{$productOrderCtrl.translations['antibody.pdp.commerceCard.promotion.learnmore']}}
产品信息
83779-4-RR
种属反应
宿主/亚型
Expression System
分类
类型
克隆号
抗原
偶联物
形式
浓度
纯化类型
保存液
内含物
保存条件
运输条件
产品详细信息
Immunogen sequence: SREGSPARS STPLHSPSPI RVHTVVDRPQ QPMTHRETAP VSQPENKPES KPGPVGPELP PGHIPIQVIR KEVDSKPVSQ KPPPPSEKVE VKVPPAPVPC PPPSPGPSAV PSSPKSVATE ERAAPSTAPA EATPPKPGEA EAPPKHPGVL KVEAILEKVQ GLEQAVDNFE GKKTDKKYLM IEEYLTKELL ALDSVDPEGR ADVRQARRDG VRKVQTILEK LEQKAIDVPG QVQVYELQPS NLEADQPLQA IMEMGAVAAD KGKKNAGNAE DPHTETQQPE ATAAATSNPS SMTDTPGNPA AP
靶标信息
BAG3 are among BAG proteins that compete with Hip for binding to the Hsc70/Hsp70 ATPase domain and promote substrate release. All the BAG proteins have an approximately 45-amino acid BAG domain near the C terminus but differ markedly in their N-terminal regions. The protein encoded by this gene contains a WW domain in the N-terminal region and a BAG domain in the C-terminal region. The BAG domains of BAG1, BAG2, and BAG3 interact specifically with the Hsc70 ATPase domain in vitro and in mammalian cells. All 3 proteins bind with high affinity to the ATPase domain of Hsc70 and inhibit its chaperone activity in a Hip-repressible manner.
仅用于科研。不用于诊断过程。未经明确授权不得转售。
篇参考文献 (0)
生物信息学
蛋白别名: BAG family molecular chaperone regulator 3; BAG-3; Bcl-2 interacting cell death suppressor; Bcl-2-associated athanogene 3; Bcl-2-binding protein Bis; Bcl-2-binding protein BIS transcript 2; BCL2 associated athanogene 3; BCL2-binding athanogene 3; DKFZp434E0610; Docking protein CAIR-1; MGC104307; unnamed protein product
基因别名: BAG-3; BAG3; BIS; CAIR-1; CMD1HH; CMT2JJ; HMND15; MFM6
UniProt ID: (Human) O95817
Entrez Gene ID: (Human) 9531